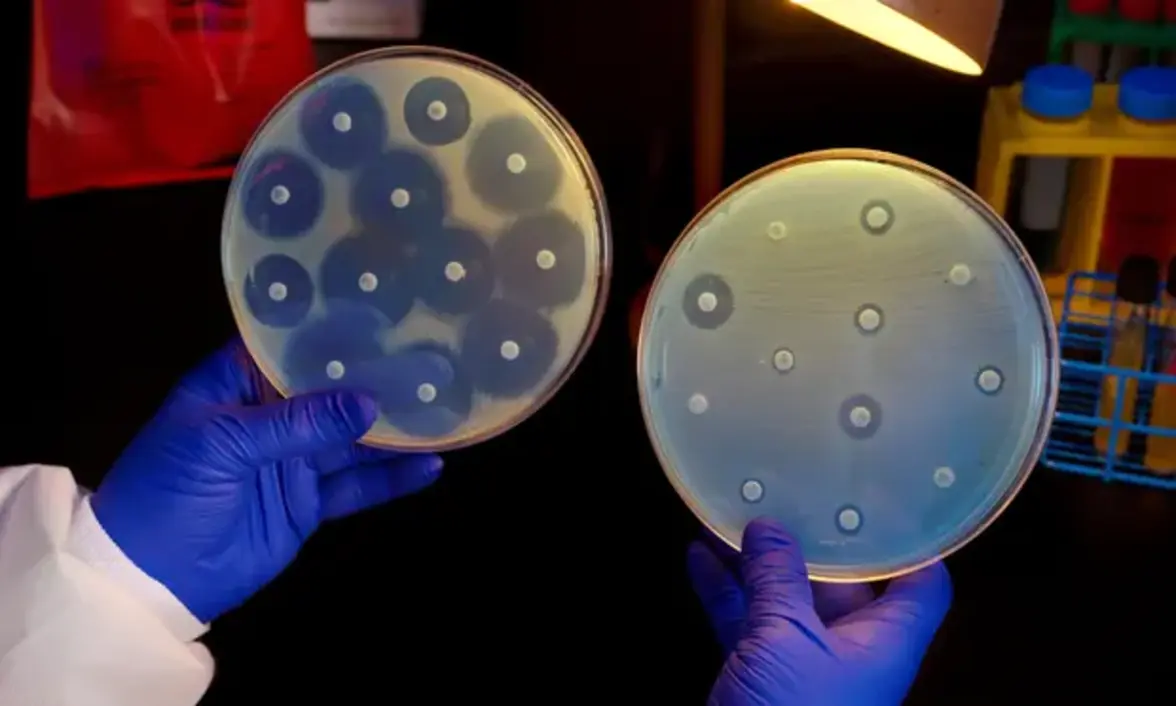
Проблемы прогнозирования резистентности к противомикробным препаратам

По оценкам, в 2019 году в мире было зарегистрировано 4,95 миллиона смертей, связанных с бактериальной резистентностью (AMR), вызванных в основном 6 патогенами: Escherichia coli, Staphylococcus aureus, Klebsiella pneumoniae, Streptococcus pneumoniae, Acinetobacter baumannii и Pseudomonas aeruginosa.
Для ограничения распространения организмов, резистентных к противомикробным препаратам (AMROs), и снижения бремени заболеваний, связанных с AMR, требуется совершенствование прогнозирования для более точной оценки возникновения и распространения AMR в популяциях и медицинских учреждениях. Однако, по состоянию на январь 2023 года, усилия по оперативному прогнозированию бремени AMROs (т.е. для реальных условий в реальном времени) не являются достаточно эффективными.
Прогнозирование инфекционных заболеваний в режиме реального времени направлено на получение оценок будущей заболеваемости на уровне популяции или сообщества, которые впоследствии могут быть оценены на основе наблюдаемых результатов. В период 2010-2020 гг. были внедрены и испытаны в реальных условиях прогностические модели для вирусных и острых инфекционных заболеваний, таких как грипп, денге и COVID-19. В отличие от этого, для AMROs не было создано и проверено ни одного прогноза. В данном материале мы обсуждаем потенциал прогнозирования AMRO в масштабах популяции и объектов, выделяем проблемы в этой области и предлагаем приоритеты будущих исследований.
Математическое моделирование AMR
Математические и статистические модели внесли свой вклад в борьбу с AMR и могут позволить прогнозировать AMR в различных масштабах. Исследования по моделированию AMRO были предприняты для выяснения факторов, связанных с AMR в масштабе популяции. Например, анализ временных рядов использовался для количественной оценки связи между использованием противомикробных препаратов и распространенностью резистентности в популяциях. Такие анализы ценны, поскольку они обычно приводят к получению ряда коэффициентов, отражающих влияние использования противомикробных препаратов на будущие показатели AMR; однако эти модели не прогнозируют распространенность AMR на будущее и не проводят строгую оценку точности прогнозирования.
Параллельно были разработаны математические модели на основе процессов для изучения передачи AMRO, моделирования конкуренции между резистентными и чувствительными штаммами и оценки влияния различных политических мер. В последнее время для представления сетей передачи и гетерогенности в медицинских учреждениях используются подробные модели на индивидуальном уровне, основанные на исторических данных о перемещении пациентов или контактах с медицинскими работниками. Эти модельные исследования обогатили понимание эволюционной динамики резистентности и динамики передачи AMRO, но не использовались для получения оперативных прогнозов AMR.
В зависимости от предполагаемого использования, прогнозирование AMRO может осуществляться на уровне популяции и на уровне учреждения. Прогнозирование на популяционном уровне направлено на предсказание тенденции распространения инфекции или носительства в общей популяции на относительно длительные периоды времени - от нескольких месяцев до нескольких лет. Для AMR-патогенов целью прогнозирования может быть количество инфекций AMR или доля изолятов, проявляющих резистентность. Эти прогнозы позволят оценить будущее бремя AMR (например, смертность, госпитализация, потерянные рабочие дни или прямые и косвенные экономические затраты) и эволюцию резистентности. Если эти прогнозы будут использоваться в режиме реального времени, они будут способствовать повышению осведомленности о ситуации и информировать политику общественного здравоохранения, такую как рациональное использование противомикробных препаратов и более целенаправленное назначение противомикробных препаратов для замедления распространения AMR.
На уровне учреждения целью прогноза может быть количество инфекций AMR с клиническими симптомами в пределах больницы или больничной системы. Такие прогнозы помогут контролировать нозокомиальную передачу AMRO и планировать ресурсы для приобретения оборудования, медикаментов, персонала и помещений в ответ на потенциальное увеличение числа пациентов. В зависимости от клинической значимости, горизонт прогнозирования может составлять несколько дней или месяцев. Следует отметить, что прогностические модели, объединяющие несколько медицинских учреждений в одном регионе, могут прояснить риск распространения AMR при межбольничной передаче пациентов и поддержать принятие решений о превентивных мерах в учреждениях без текущей передачи инфекции.
Проблемы в прогнозировании AMRO
Хотя модели и данные значительно отличаются для прогнозирования в различных масштабах, некоторые общие проблемы препятствуют разработке и оперативному использованию моделей прогнозирования AMR. Ниже мы обобщаем эти проблемы и выделяем несколько приоритетных направлений исследований для решения этих проблем в будущих исследованиях.
Для прогнозирования с помощью математических и статистических моделей очень важно понимать основные процессы, влияющие на распространение AMR. Эти процессы часто представлены в виде нелинейных эффектов в моделях прогнозирования и, если они не заданы должным образом, то прогнозы будут быстро расходиться с истиной. По состоянию на 2023 год многие вопросы, касающиеся AMR, остаются открытыми. Например, не до конца понятна роль применения антибиотиков в развитии AMR, особенно влияние совместного отбора (т.е. селекции резистентности, которая шире, чем конкретная цель назначения антимикробного препарата) и связь между амбулаторным применением антимикробных препаратов и резистентными инфекциями у госпитализированных пациентов. В целом, пока неизвестно, какой тип использования противомикробных препаратов (например, использование в сообществах, в стационарах или в ветеринарии) оказывает наибольшее влияние на возникновение AMR. После появления AMRO остается неясным, как конкуренция с чувствительными штаммами влияет на частоту появления резистентных штаммов и как объяснить их сосуществование в течение длительных периодов времени. Аналогичным образом, вопрос распространения (т.е. передачи AMR между локациями), вероятно, является серьезной проблемой для прогнозирования, которая до сих пор не решена.
В медицинских учреждениях неизвестно, как контакты и неоднородность воздействия антибиотиков определяют распространение AMR; трудно разделить роли общественного импорта и нозокомиальной передачи; трудно количественно оценить относительную трансмиссивность между категориями людей (пациенты, медицинские работники) и окружающей средой. Кроме того, причинно-следственные связи на индивидуальном уровне между типом и продолжительностью терапии и возникновением резистентности в большинстве случаев остаются неизвестными.
Микробиом человека также служит резервуаром резистентности к противомикробным препаратам, однако многие нерешенные научные вопросы, касающиеся влияния микробиома, по состоянию на январь 2023 года все еще находятся в стадии активного изучения. Необходимы дальнейшие исследования для изучения роли отбора побочных микроорганизмов (т.е. отбора резистентности у микроорганизмов, не являющихся целевыми патогенами) в возникновении AMR, причин, по которым лечение цефалоспоринами является фактором риска колонизации ванкомицин-резистентного энтерококка, а также разницы между выявляемой колонизацией и колонизацией высокого уровня.
На сегодняшний день прогнозирование инфекционных заболеваний в основном сосредоточено на острых вирусных инфекциях, для которых возбудитель и его заболевание или клинический исход могут быть напрямую связаны. Например, вирусная нагрузка обычно коррелирует с инфекционностью и фенотипом заболевания (от легкого до тяжелого) и, следовательно, с заболеваемостью и смертностью. Эти корреляции делают определение цели прогнозирования (например, показатели заболеваемости, госпитализации или смертности) относительно простым. Однако для бактериальных или грибковых видов взаимосвязь между патогенной нагрузкой и клиническими исходами неясна. Поскольку многие виды бактерий являются комменсалами своих хозяев и имеют различную вероятность присутствия на разных участках тела, сложно однозначно определить, колонизирован ли человек. Без точного наблюдения за колонизацией бремя AMR не может быть точно определено и, следовательно, его сложнее прогнозировать.
Прогнозирование в основе своей является задачей, основанной на данных. Без достаточного количества данных прогностические модели не могут быть должным образом подготовлены и оценены. По состоянию на 2023 год, данных, которые могут помочь в составлении оперативно полезных прогнозов в отношении AMR, по-прежнему мало. На популяционном уровне существует несколько систем эпиднадзора. Например, Национальная система мониторинга устойчивости к противомикробным препаратам для энтеральных бактерий США отслеживает изменения в чувствительности к противомикробным препаратам определенных энтеральных бактерий у больных людей, в розничной торговле мясом и пищевыми животными. Однако в большинстве стран, особенно в странах с низким и средним уровнем дохода, а также в странах с развивающимися AMRO с ограниченным числом случаев, отсутствуют последовательные долгосрочные записи профилей возбудителей AMR. Кроме того, несколько основных патогенов, ответственных за инфекции, связанные с оказанием медицинской помощи, не учитываются в эпиднадзоре.
На уровне учреждения данные о AMR в последние годы становятся все более доступными для исследователей. В медицинских учреждениях больше внимания уделяется инфицированным пациентам с клиническими проявлениями. Надзор за бессимптомным носительством AMRO не является приоритетным, поскольку оно не представляет непосредственного клинического интереса, хотя такие носители играют важную роль в дальнейшей передаче инфекции. Такое неполное наблюдение затрудняет оценку общей распространенности AMRO и может привести к необъективным целям прогнозирования. Кроме того, трудно собрать данные о небиологических процессах, способствующих передаче возбудителей AMR, таких как поведение пациентов и взаимодействие с медицинскими работниками. В тех случаях, когда соответствующие данные доступны, качество данных может быть низким, поскольку записи могут содержать ошибки и неправильную классификацию. Даже в структурированных данных как прогностические переменные, так и результаты (например, колонизация) могут страдать от отсутствия достаточных данных.
Калибровка моделей - это процесс, в ходе которого математическая модель настраивается для воспроизведения эмпирических наблюдений. Хотя этот процесс не гарантирует точного прогнозирования, калибровка модели обеспечивает первоначальную проверку того, что модель может точно воспроизвести исторические данные. Исследования, калибрующие модели AMR по эмпирическим данным, были опубликованы. Однако, поскольку структура моделей AMR становится все более сложной, возникают вычислительные трудности при подгонке этих моделей к наблюдениям различных типов и в различных масштабах. Например, распространенность на уровне популяции, результаты тестов на индивидуальном уровне и геномные последовательности патогенов передают различные части информации о передаче AMR, и калибровка моделей AMR с учетом этих наблюдений одновременно является сложной задачей. Передача AMRO по своей природе стохастична и имеет большую неопределенность. Количественная оценка неопределенности прогнозов, полученных с помощью сложных моделей AMR, затруднена, особенно для моделей, которые отслеживают отдельных людей и их контакты. Подходы к калибровке и их успех обычно зависят от конкретной конструкции модели и формы наблюдений.
Одной из важных проблем прогнозирования AMRO является оперативная реализация и перспективная оценка прогностических моделей (т.е. составление прогнозов в реальном времени и оценка этих прогнозов после наблюдения за объектами прогнозирования). Для прогнозирования AMRO не существует руководящих принципов реализации. Остаются открытыми вопросы о надлежащем временном масштабе горизонта прогнозирования, частоте, с которой необходимо обновлять модели, и фундаментальном пределе предсказуемости моделей. Для долгосрочного прогнозирования требуется последовательный сбор данных в течение длительного периода времени. В медицинских учреждениях практика тестирования и отчетности по AMR-инфекциям может меняться со временем, что еще больше усложняет использование таких записей данных и оценку прогноза. Совместные усилия, которые стандартизируют учебные массивы данных, цели прогнозирования, горизонты прогнозирования и надлежащие правила подсчета баллов для оценки эффективности прогноза, могут потенциально стимулировать прогресс в оперативном прогнозировании AMR.
Особой проблемой для реализации прогнозирования AMRO является учет неопределенности в прогнозах; неопределенность существует из-за несовершенства данных и заметной степени изменчивости многих процессов, связанных с AMR. Количественная оценка такой неопределенности является критически важной в других областях прогнозирования, таких как прогнозирование погоды. Для AMRO, будь то на уровне учреждения (например, определение того, какие пациенты должны соблюдать меры предосторожности при контакте) или на уровне сообществ (например, чиновники общественного здравоохранения дают рекомендации по назначению лекарственных препаратов в связи с AMR), лица, принимающие решения, должны принимать решения, используя неопределенную информацию. Эта истина справедлива как для наблюдений, так и для прогнозов. Разработка оптимальных систем принятия решений и архитектур, которые наилучшим образом используют прогнозы, учитывая их неопределенность, является необходимой долгосрочной целью.
Эффективные коммуникации между разработчиками моделей и заинтересованными сторонами, такими как чиновники общественного здравоохранения, медицинские учреждения и отдельные практикующие врачи, имеют решающее значение для изучения их практических потребностей в моделировании AMR. Однако в научных журналах отсутствуют официальные отчеты, фиксирующие такие контакты, что является еще одним фактором, ограничивающим составление и использование оперативных прогнозов в реальных условиях.
Чтобы проиллюстрировать взаимосвязанные проблемы, с которыми сталкивается прогнозирование AMRO в разных масштабах, мы используем метициллин-резистентный золотистый стафилококк (MRSA) в качестве конкретного примера. Несколько ключевых вопросов прогнозирования MRSA в масштабах учреждения, популяции и в разных масштабах остаются нерешенными; один из них заключается в том, что неизвестны конкретные данные, необходимые для моделирования в этих разных масштабах, а также роль совместного отбора и конкуренции с чувствительным к метициллину S. aureus (MSSA) во влиянии на динамику MRSA. Ответы на эти вопросы позволят улучшить методы снижения бремени MRSA как в сообществе, так и в больничных условиях.
В данной перспективе мы сосредоточились на прогнозировании AMRO в режиме реального времени. Параллельным направлением исследований является моделирование на основе сценариев, которое прогнозирует инфекции AMR в зависимости от предполагаемых изменений в предписанных вмешательствах или ожидаемых условиях. Предыдущие исследования по борьбе с ВИЧ и туберкулезом показывают, что такие сценарные прогнозы могут существенно повлиять на политику здравоохранения и спасти жизни людей. Для AMR прогнозы на основе сценариев должны быть разработаны для решения практических вопросов в области общественного здравоохранения и информирования о принятии оперативных политических решений в режиме реального времени, возможно, с использованием комбинированных подходов, объединяющих несколько моделей для отражения различий между ними. Прогнозирование в реальном времени и прогнозирование на основе сценариев дополняют друг друга и должны разрабатываться в тандеме для контроля бремени AMR и улучшения здоровья человека.
Несмотря на все эти проблемы, исследования все еще можно проводить, используя имеющиеся в настоящее время данные и ресурсы. Например, можно проверить осуществимость и полезность прогнозирования распространенности AMR на уровне населения в режиме реального времени, используя существующие данные эпиднадзора. Такая проверка может стимулировать исследовательское сообщество к решению первых практических вопросов по разработке прогноза (например, какие переменные должны быть включены? Каков подходящий горизонт прогнозирования? Как оценивать качество прогноза?).
Повышение доступности существующих данных также может ускорить прогресс. Электронные медицинские карты содержат множество данных о AMR, каждая из которых отражает определенный аспект процессов, связанных с AMR. Синтез ранее разрозненных массивов данных в математические модели потенциально может дать ответы на научные вопросы, которые трудно решить, используя каждый массив данных в отдельности. Обмен данными между объектами с сохранением конфиденциальности может увеличить количество данных для моделирования и поддержать разработку обобщающих методов. Если обмен данными нецелесообразен, можно обмениваться моделями и алгоритмами, обучать их и внедрять при соблюдении определенных стандартов и контроля качества.
Будущие возможности прогнозирования
Учитывая существующие пробелы в прогнозировании AMR, прогностические модели все еще недостаточно зрелы для оперативного применения. Чтобы продвинуться вперед в этой развивающейся области, необходимо определить приоритетность нескольких направлений исследований.
Во-первых, улучшение коммуникации между различными отраслями и заинтересованными сторонами, включая академических исследователей, агентства общественного здравоохранения, медицинских работников и общественность, поможет определить ключевые вопросы и потребности конечных пользователей прогнозных моделей. Разработка и применение прогнозирования AMR будут коллективными усилиями, которые должны решить реальные вопросы в области общественного здравоохранения и ухода за пациентами.
Во-вторых, исследования должны более эффективно использовать существующие данные и направлять сбор новых данных, которые необходимы для понимания AMR. Инвестирование в последовательное наблюдение и сбор данных имеет огромное значение для улучшения понимания возникновения, распространения и результатов AMR.
В-третьих, для калибровки сложных моделей AMR на основе многотипных и многомасштабных данных необходимы более эффективные алгоритмы, требующие больших вычислительных затрат. Лучшая интерпретируемость моделей может вселить уверенность в клиницистов при использовании этих методов. Кроме того, исследование вычислительных методов, предназначенных для прогнозирования AMR, может помочь соединить теоретические модели и реальные приложения.
В-четвертых, прогностические модели AMR должны быть реализованы в реальных условиях в режиме реального времени, чтобы можно было оценить их практическую пользу путем проверки оперативных прогнозов в режиме реального времени, как это делается для прогнозирования погоды. Прогностические навыки, включая точность и неопределенность прогноза, должны быть оценены, чтобы подтвердить, что прогностические модели могут давать полезные прогнозы, несмотря на наличие помех и неполноту данных.
В целом, несмотря на уроки, извлеченные из последних достижений в прогнозировании других острых инфекционных заболеваний, прогнозирование AMRO имеет свой собственный набор проблем, включая широкое и длительное бессимптомное носительство, более длительные временные рамки, непрерывную эволюцию из-за конкуренции штаммов и использования противомикробных препаратов, а также плохо наблюдаемую тяжесть заболевания. Очень важно установить соответствующие ожидания в отношении эффективности прогнозирования AMRO и выработать разумные критерии для успешного прогнозирования.